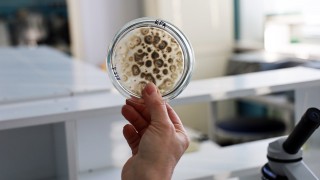
AGTU, kuraklığa dayanıklı mikroorganizmalı biyogübre geliştirdi

Gaziantep'te yaklaşık 30 ton buğday yüklü tırı boşaltmadan kaçan tır şoförü, kayıplara karıştı.
Gaziantep'te yaklaşık 30 ton buğday yüklü tırı boşaltmadan kaçan tır şoförü, kayıplara karıştı.
Oğuzeli ilçesine bağlı Taşçanak Mahallesi'nde buğday yükleyen ismi öğrenilemeyen 06 DIJ 71 plakalı tır sürücüsü, tırı boşaltmak için dün sabah saatlerinde kent merkezindeki bir depoya geldi. Depoda kantara giren ve tırı boşaltmak sıraya giren tır şoförü, tırı boşaltmadan sıradan ayrıldı. Sabah saatlerinde depoya gelen yaklaşık 30 ton buğdayın sahibi olan çiftçi M.Ö., tırın yerinde olmadığını fark etti. Tırın yaklaşık 30 ton yüklü buğdayla kayıplara karıştığını anlayan mal sahibi, durumu polise bildirdi. İhbar üzerine olay yerine gelen polis, plakası belirlenen tırın bulunması için çalışma başlattı.
Mal sahibi M.Ö., tıra buğday yüklerken cep telefonuyla tırı kayda aldığı görüldü.
"Bölgemizde ilk defa böyle bir olay oldu"
Buğday yüklü tırın çalınmasıyla şaşkına döndüklerini belirten mal sahibi M.Ö.'nün akrabası Türkey Tamer, "İki önce çağrılan tırla akrabam buğdayını yükleyip Gaziantep'e gönderdi. Deponun önünde satış için beklerken bir anda ortadan kaybolduğunu öğrendik. Bu konuda mağdur bir duruma düştük. İnsanlara bildiriyoruz, dikkatli olsunlar. Bu bölgede kendimi bildim bileli böyle bir olay yaşanmadı. Gerçekten bu konuda yetkililerden yardım bekliyoruz. Bir yıl boyunca emek verildi ve emeğimiz boşuna gitmiş oldu. Buğday yüklü tırın biran önce bulunmasını istiyoruz" dedi.
Tırın bulunması için başlatılan soruşturma sürdürülüyor.

Yorum Yazın